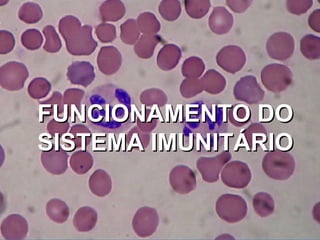
FUNCIONAMENTO DO SISTEMA IMUNITÁRIO

Este documento fornece um resumo abrangente sobre a Síndrome da Imunodeficiência Adquirida (SIDA), incluindo sua causa (o vírus HIV), sintomas, transmissão, tratamento e prevenção. Explica como o HIV destrói o sistema imunológico, levando a doenças oportunistas, e descreve o ciclo de vida do vírus dentro das células. Também discute os tipos de medicamentos antirretrovirais usados para tratar a infecção e seus objetivos de redu